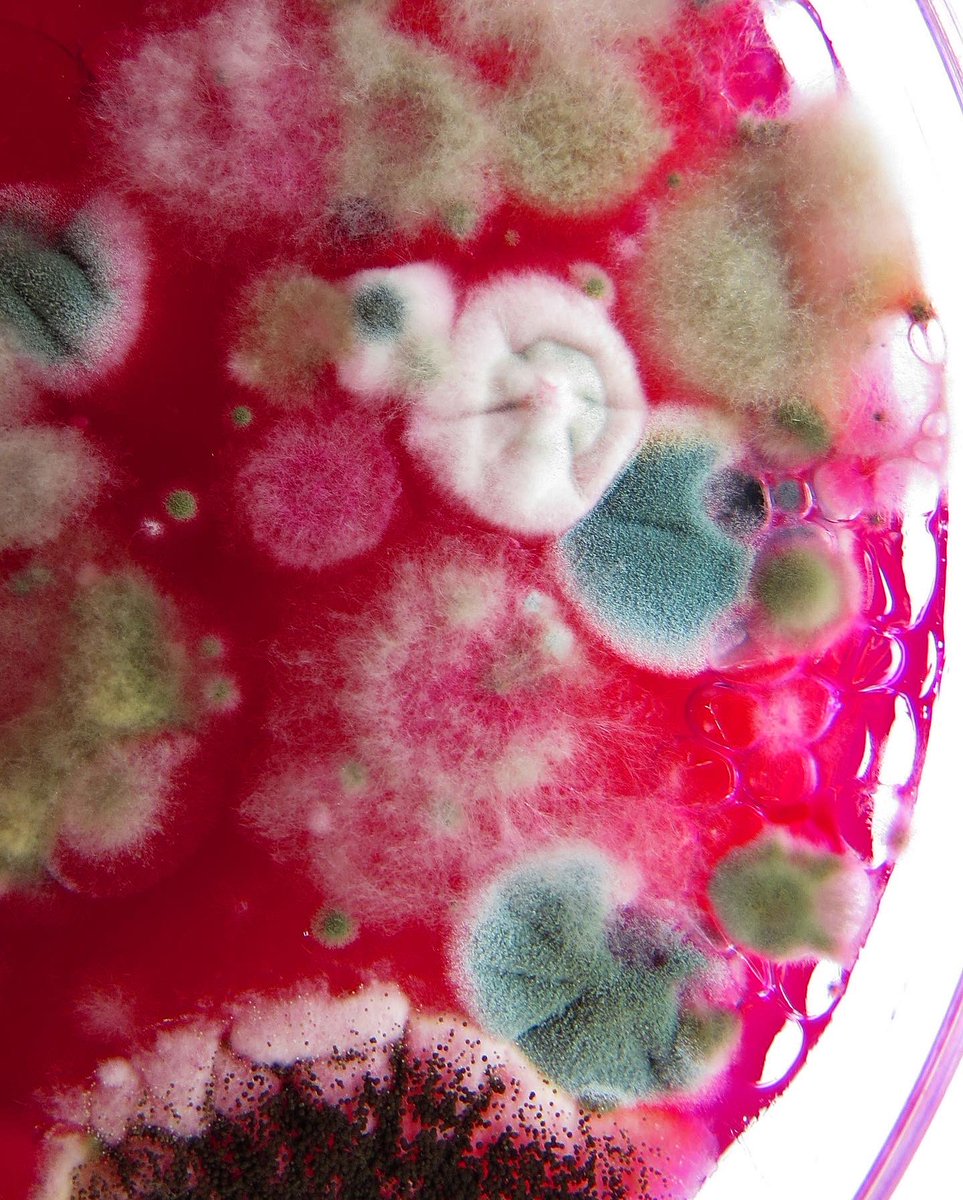
Playing with colours and textures🤤

DashaPlesen
@dashaplesen
Molds and miracles 👽🌱💜
ID: 1370743028927889408
http://instagram.com/dashaplesen 13-03-2021 14:26:39
20 Tweet
141 Followers
7 Following








Petri dishes of mold, spores and household objects by DashaPlesen uncover the art of decomposition coolhunting.com/culture/dasha-…



Some STEAM collaboration taking place in the Art department this morning… Year 12 have been exploring the work of DashaPlesen using marbled paper, textiles elements and lightboxes to capture mold samples in interesting ways. Thanks to the HarrowHK Science for their support!